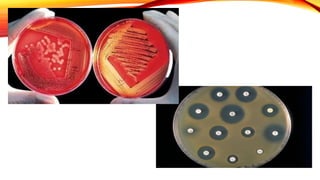

O documento discute o uso de antimicrobianos em medicina veterinária. Apresenta conceitos gerais sobre quimioterápicos antimicrobianos, classificação de acordo com o mecanismo de ação e espectro, assim como exemplos de antibióticos bactericidas e bacteriostáticos. Também aborda o uso correto de antimicrobianos em termos de escolha do agente, posologia e associações, além de efeitos adversos comuns.

![QUINOLONAS
Distribuição:
Largo volume de distribuição, baixa ligação com prot. Plasmáticas
SNC
Ossos
Próstata
Biotransformação
Parcialmente biotransformadas
Eliminação pelos rins
[ ] urina - uso infecções urinárias](https://image.slidesharecdn.com/16032023100628aula5e6antimicrobianos-230327033852-6840bf24/85/Aula-antimicrobianos-pptx-34-320.jpg)

















































